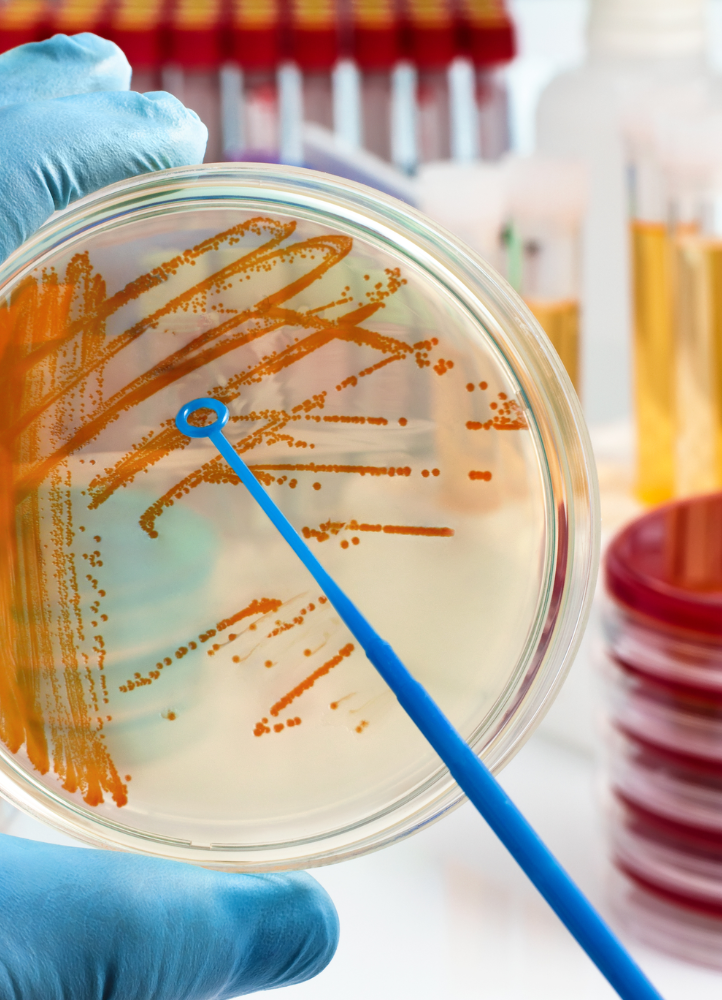

Analisi del sangue e diagnostica di laboratorio
Chimica clinica
Ematologia
Dosaggi ormonali
Coagulazione
Ormoni Tiroidei
Dosaggi ormonali
Dosaggi ormonali
Dosaggi ormonali
Dosaggi ormonali
Dosaggi ormonali
Esami accurati per monitorare il tuo stato di salute e ottenere risultati affidabili in tempi rapidi.
Test per allergie e intolleranze alimentari
Celiachia
Autoimmunità
Microbiologia
Parassitologia
Tossicologia
Urine
Intolleranze alimentari con Cytotoxic Test ®
Analisi chimiche
Analisi veterinarie
Indagini specifiche per individuare allergie e intolleranze e migliorare il tuo benessere quotidiano.
Prenota il tuo esame oggi e ricevi risultati affidabili in tempi rapidi!
In Eurolab ci prendiamo cura della tua salute con professionalità e precisione. Offriamo una vasta gamma di analisi cliniche e diagnostiche, utilizzando strumenti all’avanguardia per garantire risultati accurati in tempi rapidi.



